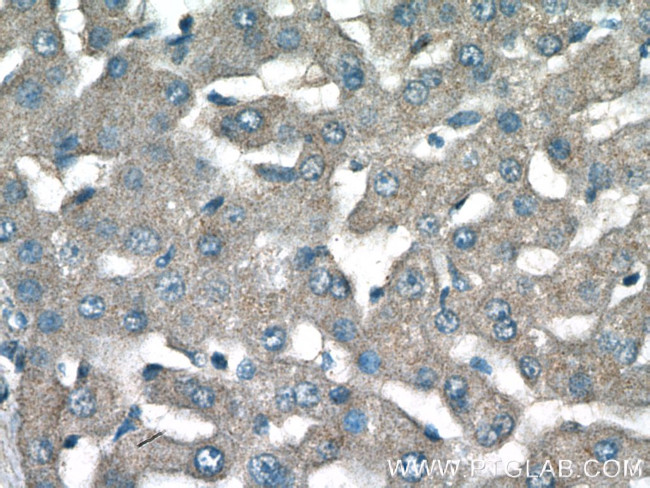
NPC2 Antibody in Immunohistochemistry (Paraffin) (IHC (P))

Search
Proteintech
NPC2 Polyclonal Antibody
{{$productOrderCtrl.translations['antibody.pdp.commerceCard.promotion.promotions']}}
{{$productOrderCtrl.translations['antibody.pdp.commerceCard.promotion.viewpromo']}}
{{$productOrderCtrl.translations['antibody.pdp.commerceCard.promotion.promocode']}}: {{promo.promoCode}} {{promo.promoTitle}} {{promo.promoDescription}}. {{$productOrderCtrl.translations['antibody.pdp.commerceCard.promotion.learnmore']}}
产品信息
19888-1-AP
种属反应
已发表种属
宿主/亚型
分类
类型
抗原
偶联物
形式
浓度
规格
纯化类型
保存液
内含物
保存条件
运输条件
产品详细信息
Immunogen sequence: MRFLAATFL LLALSTAAQA EPVQFKDCGS VDGVIKEVNV SPCPTQPCQL SKGQSYSVNV TFTSNIQSKS SKAVVHGILM GVPVPFPIPE PDGCKSGINC PIQKDKTYSY LNKLPVKSEY PSIKLVVEWQ LQDDKNQSLF CWEIPVQIVS HL (1-151 aa encoded by BC002532)
靶标信息
This gene encodes a protein containing a lipid recognition domain. The encoded protein may function in regulating the transport of cholesterol through the late endosomal/lysosomal system. Mutations in this gene have been associated with Niemann-Pick disease, type C2 and frontal lobe atrophy.
仅用于科研。不用于诊断过程。未经明确授权不得转售。
生物信息学
蛋白别名: epididymal protein 1; Epididymal secretory protein E1; epididymis secretory sperm binding protein; He1; Human epididymis-specific protein 1; mE1; MGC1333; Niemann Pick type C2 protein homolog; Niemann-Pick disease type C2 protein; NP-C2; NPC intracellular cholesterol transporter 2; tissue-specific secretory protein; unnamed protein product
基因别名: 2700012J19Rik; AA408070; AU045843; EDDM1; HE1; NPC2
UniProt ID: (Human) P61916, (Mouse) Q9Z0J0
Entrez Gene ID: (Human) 10577, (Mouse) 67963